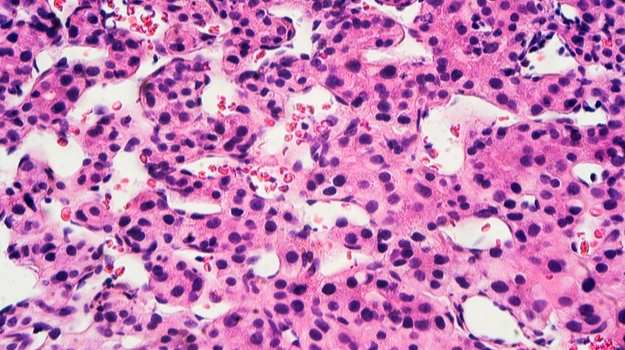
Opdivo和Yervoy组合赢得了HCC的加速批准 ,stylechina.com

美国食品和药物管理局(FDA) 发表了加速绿光到Bristol Myers Squibb的 Opdivo和Yervoy的的组合作为肝癌患者谁与拜耳公司的多吉美(索拉非尼)治疗过治疗。
组合治疗的批准基于I / II期CheckMate-040试验的结果,其中Opdivo和Yervoy在该患者人群中的总体缓解率为33%。其中,有8%的人有完全缓解,有24%的人有部分缓解stylechina.com。BMS表示,反应持续时间(DOR)为4.6至30.5个月,其中88%持续至少六个月,56%至少持续12个月,31%至少持续24个月。
BMS的首席研究员兼南加州大学凯克医学院的I期计划主任Anthony B. El-Khoueiry说,在CheckMate-040试验的Opdivo和Yervoy组合中观察到的总体缓解率强调了这种双重免疫疗法可能会成为患者的治疗选择。
Opdivo(nivolumab)和Yervoy(ipilimumab)是BMS免疫学治疗的基石。Opdivo是一种程序性死亡1(PD-1)免疫检查点抑制剂,已被批准用于治疗多种癌症,包括先前接受过抗血管生成治疗的晚期肾细胞癌患者。Yervoy靶向调节免疫系统的蛋白质受体CTLA-4。
FDA在加速批准下点头。该公司指出,这种适应症的持续批准可能取决于验证试验中对临床益处的验证和描述。BMS说,Opdivo和Yervoy的组合是在这种情况下首个也是唯一被批准的双重免疫疗法。该公司补充说,这是FDA批准的第四种联合治疗癌症的法规。先前已为该适应症授予了突破性治疗称号和FDA的优先审查。
肝细胞癌(HCC)是成年人中最常见的肝癌类型。肝癌约占所有原发性肝癌的80%。该疾病最常发生于患有慢性肝病的人,例如由乙型肝炎或丙型肝炎引起的肝硬化。
布里斯托尔·迈尔斯·斯奎布(Bristol Myers Squibb)总经理兼美国肿瘤学,免疫学和心血管学部门负责人亚当·兰科斯基(Adam Lenkowsky)表示,迫切需要为患有侵袭性癌症的患者(例如HCC)提供新的治疗选择,这些选择可能“具有临床意义并最终产生持久的反应。” 伦科夫斯基说,这项批准是基于该公司在开创性免疫疗法治疗方面的传统。
Blue Faery主席兼创始人:Adrienne Wilson肝癌协会主席安德里亚·威尔逊(Andrea Wilson)表示:“在美国,肝癌的发病率正在上升,而肝癌是最常见和侵略性的疾病。“今天的批准为以前接受索拉非尼治疗的HCC患者提供了新的选择,给社区带来了更多希望。”
去年,礼来制药(Eli Lilly)取消了Cyramza的监管批准,将其作为具有甲胎蛋白(AFP)且以前接受过索拉非尼治疗的肝细胞癌(HCC)二线治疗的单一药物。同样在2019年,总部位于加利福尼亚阿拉米达的Exelixis,Inc.获得了其HCC治疗药物Cabometyx(cabozantinib)的批准。